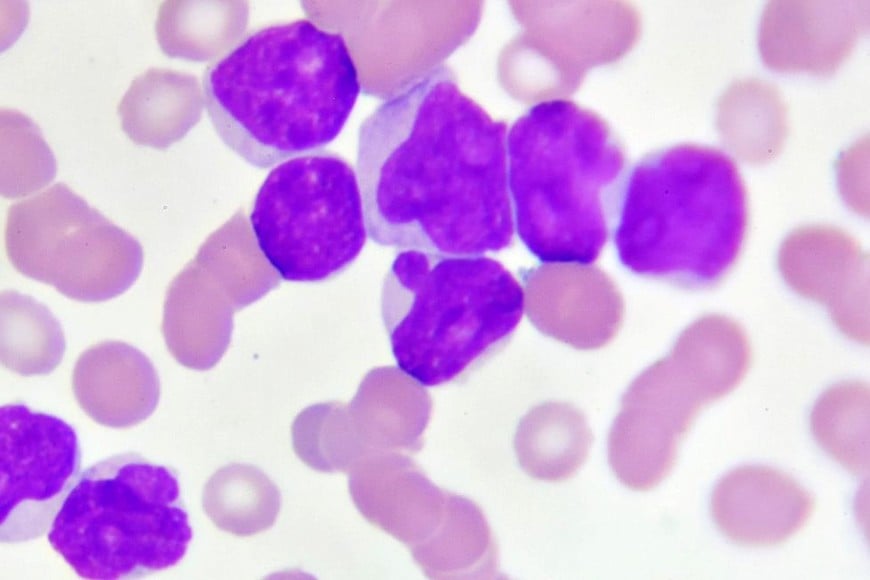
Se la denomina “crónica” debido a que su progresión suele darse lentamente.

La abogada Ana Rosenfeld contó detalles sobre cómo atraviesa su defendida Wanda Nara, la leucemia mieloide crónica, en el inicio de 2024.
Cómo atraviesa Wanda Nara su enfermedad y cómo es el novedoso tratamiento que ofrece Fundaleu
La Fundación desarrolló un nuevo tratamiento para pacientes con leucemia mieloide crónica resistentes o intolerantes a otras terapias.

El diagnóstico golpeó a Wanda el año pasado y desde entonces, con mucho esfuerzo, le puso el pecho a la situación y comenzó un tratamiento.
Al ser consultada por el presente de su defendida, Rosenfeld dijo: “Ella está en un muy buen año, profesional y, por supuesto, se está ocupando muchísimo de su salud, porque yo sé que eso es un tema que siempre preocupa, el saber cómo está”.
“Wanda no es solamente en Argentina una mujer querida y respetada, también lo es en el mundo. Y yo digo esto porque, como su asesora jurídica, me la paso firmando contratos. Inclusive ahora ella quería ir unos días a Punta del Este pero no pudo porque tuvo que ir a Brasil a trabajar por su desarrollo musical. Y la suerte es que Mauro la acompaña en todo, yo creo que hubo un cambio radical en él, yo lo quiero muchísimo”, agregó en Mañanisima (El Trece).

En Argentina, se detectan más de 3200 casos de leucemia de forma anual, de acuerdo al último relevamiento realizado por el Instituto Nacional del Cáncer. De esta cifra, la leucemia mieloide crónica representa entre el 15 y 20 por ciento, lo que se traduce en una media de entre 500 y 600 nuevos diagnósticos anuales.
La leucemia es un tipo de cáncer que se origina cuando las células productoras de la sangre en la médula ósea mutan para convertirse en una célula leucémica. Al realizar este paso, ya no madura de la manera en la que debería. “Hay cuatro tipos principales de leucemia, cada uno designado en base a la velocidad a la que la enfermedad se desarrolla y empeora, así como al tipo de células sanguíneas afectadas”, según resaltan desde el CRI.
Qué es la leucemia mieloide crónica
La leucemia mieloide crónica (LMC), también conocida como leucemia mielógena o mieloblástica crónica, se desarrolla cuando la mutación tiene lugar en la célula madre hematopoyética. Se la denomina “crónica” debido a que su progresión suele darse lentamente.
Tiene una incidencia de 1-2 casos cada 100.000 personas y aunque se puede presentar en cualquier grupo etario, la mediana de edad para el comienzo de la enfermedad es de 67 años, siendo que constituye el 15% de las leucemias en pacientes adultos.

La LMC forma parte de las enfermedades Neoplasias Mieloproliferativas, cuya evolución es lenta.
Los diagnósticos de la misma se realizan en una fase asintomática y poco agresiva llamada fase crónica. Con el uso de distintos fármacos, la probabilidad de progresión es menor del 10%.
Nuevo tratamiento
Se desarrolló un nuevo tratamiento para pacientes con leucemia mieloide crónica resistentes o intolerantes a otras terapias. Denominado en la Argentina como Asciminib, esta innovadora terapia cuenta con un novedoso mecanismo de acción y está indicada para pacientes que no respondieron o presentaron toxicidad a otras terapéuticas ya disponibles.
“La leucemia mieloide crónica es una enfermedad que se origina por un desorden en la médula ósea que produce un aumento de glóbulos blancos anormales. En algunos casos, también afecta otras células u órganos manifestándose como cansancio secundario a la disminución de glóbulos rojos (anemia), sangrados o hematomas por alteración de las plaquetas, disconfort abdominal consecuencia del aumento del bazo y pérdida de peso”, señaló la doctora Carolina Pavlovsky (MN 93.882), médica hematóloga, jefa de Investigación en FUNDALEU.
En ese sentido, la especialista explicó que el responsable de que la enfermedad se desencadene es “un cromosoma anormal llamado cromosoma Filadelfia que se forma por cambios en el cromosoma 9 y el 22 y gatilla todo este desorden. Todos estos cambios se pueden detectar en un análisis de laboratorio de rutina”.
Según se desprende de las guías de tratamiento publicadas recientemente por la Sociedad Argentina de Hematología, en la actualidad existen “cuatro Inhibidores de Tirosina Kinasa (ITKs) aprobados como tratamiento de primera línea para pacientes con leucemia mieloide crónica”. Y la elección de cada fármaco está vinculada al “objetivo del tratamiento, la edad del paciente, sus comorbilidades, la disponibilidad y perfil de efectos adversos de las drogas que aseguren la continuidad del tratamiento”.
“El objetivo principal es lograr una respuesta óptima para alcanzar una sobrevida similar a la de la población general”, indicó el documento. En los casos en que ninguno de estos cuatro fármacos es pertinente en el tratamiento, ya sea por intolerancia al ITK de primera línea o por falta de respuesta, los pacientes deben recibir otra línea más avanzada de tratamiento.

“En este sentido, es que necesitamos nuevas opciones para este grupo de pacientes que ya han pasado por varias líneas de tratamiento o para aquellos pacientes que son intolerantes al tratamiento que están recibiendo”, destacó la especialista. Quien señaló, además, que “los estudios de investigación muestran altas tasas de eficacia y excelente tolerancia, con mínimos efectos secundarios”
De este modo, esta nueva terapéutica puede ser un punto de inflexión. “Este nuevo tratamiento cubre una necesidad insatisfecha, ya que presenta un mecanismo de acción nuevo y distinto comparado con los tratamientos previos”, indicó Pavlovsky al analizar Asciminib, la nueva terapéutica para la LMC desarrollada por el laboratorio Novartis, que fue aprobada recientemente en la Argentina.
Es que esta terapéutica “permite que la célula maligna resistente a tratamientos previos pueda ser atacada y no se resista”. Se trata, según indicó, del “primer y único inhibidor del ABL STAMP (siglas en inglés de Specifically Targeting the ABL Myristoyl Pocket)”. “Este mecanismo de acción es único y puede significar que mantendría la actividad contra las mutaciones de resistencia, en comparación con los ITK clásicos”, detalló la especialista y recalcó que la evidencia disponible da cuenta de que su perfil de tolerabilidad es favorable.
Al tiempo que, para finalizar, señaló que esta terapia está indicada “para el tratamiento de pacientes adultos con leucemia mieloide crónica con positividad para el cromosoma Filadelfia en fase crónica, tratados previamente con dos o más Inhibidores de Tirosina-Cinasas (ITKs) y para pacientes con leucemia mieloide crónica que presentan la mutación T315I”.









Dejanos tu comentario
Los comentarios realizados son de exclusiva responsabilidad de sus autores y las consecuencias derivadas de ellos pueden ser pasibles de las sanciones legales que correspondan. Evitar comentarios ofensivos o que no respondan al tema abordado en la información.